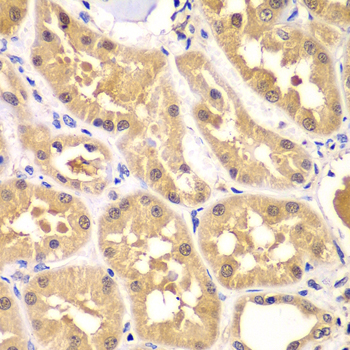
Immunohistochemistry - PRKAG3 Polyclonal Antibody

-
Product Name
PRKAG3 Polyclonal Antibody
- Documents
-
Description
Polyclonal antibody to PRKAG3
-
Tested applications
IHC, IF
-
Species reactivity
Human
-
Alternative names
PRKAG3 antibody; AMPKG3 antibody; 5'-AMP-activated protein kinase subunit gamma-3 antibody
-
Isotype
Rabbit IgG
-
Preparation
Antigen: Recombinant fusion protein containing a sequence corresponding to amino acids 1-210 of human PRKAG3 (NP_059127.2).
-
Clonality
Polyclonal
-
Formulation
PBS with 0.02% sodium azide, 50% glycerol, pH7.3.
-
Storage instructions
Store at -20℃. Avoid freeze / thaw cycles.
-
Applications
IHC 1:50 - 1:200
IF 1:50 - 1:100 -
Validations
Immunohistochemistry - PRKAG3 Polyclonal Antibody
Immunohistochemistry of paraffin-embedded human kidney using PRKAG3 antibody at dilution of 1:100 (40x lens).
-
Background
AMP/ATP-binding subunit of AMP-activated protein kinase (AMPK), an energy sensor protein kinase that plays a key role in regulating cellular energy metabolism. In response to reduction of intracellular ATP levels, AMPK activates energy-producing pathways and inhibits energy-consuming processes: inhibits protein, carbohydrate and lipid biosynthesis, as well as cell growth and proliferation. AMPK acts via direct phosphorylation of metabolic enzymes, and by longer-term effects via phosphorylation of transcription regulators. Also acts as a regulator of cellular polarity by remodeling the actin cytoskeleton; probably by indirectly activating myosin. Gamma non-catalytic subunit mediates binding to AMP, ADP and ATP, leading to activate or inhibit AMPK: AMP-binding results in allosteric activation of alpha catalytic subunit (PRKAA1 or PRKAA2) both by inducing phosphorylation and preventing dephosphorylation of catalytic subunits. ADP also stimulates phosphorylation, without stimulating already phosphorylated catalytic subunit. ATP promotes dephosphorylation of catalytic subunit, rendering the AMPK enzyme inactive.
Related Products / Services
Please note: All products are "FOR RESEARCH USE ONLY AND ARE NOT INTENDED FOR DIAGNOSTIC OR THERAPEUTIC USE"
